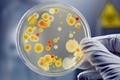

Відтепер на Корюківщині два будинки сімейного типу. Один у самій Корюківці, другий у сільській місцевості. Новий будинок сімейного типу створила 48-річна мама, у якої до цього часу була прийомна родина з чотирма дітьми.

Сьогодні в мікрорайоні Нова Подусівка у приватному будинку із заґратованими вікнами правоохоронці припинили діяльність так званого «реабілітаційного центру з ідеологічним одужанням», де проти волі утримувалися два десятки людей віком від 18 до 50-ти років.

Приїзд до Чернігова 91-річної художниці, шістдесятниці Галини Севрук став головною подією на фестивалі монументального мистецтва. Легендарну мисткиню запросили на презентацію її панно «Давній Чернігів» або «Міста-побратими».

Дві людини померли від ботулізму минулого тижня в Чернігові. Які симптоми хвороби та як уберегтися?
Про це говорили з Оксаною Баластрик, лікаркою-інфекціоністом.

У Чернігові навчальний рік закінчиться 4 червня. Учні 9-тих класів отримають атестати 9 червня. А випускники 11 класів - 30 червня та 1 липня. Про це повідомила заступниця начальника управління освіти Олена Горна на розширеній нараді у міськраді.

Станом на 18 травня Чернігівська область, як і більшість областей України, знаходиться у жовтій зоні за рівнем епідемічної небезпеки по розповсюдженню коронавірусної інфекції. По місту Чернігову за дев’ятнадцятий тиждень стабільно, але повільно зменшується кількість захворілих та госпіталізованих.

18 травня о 22:00 розпочнеться перший півфінал щорічного пісенного конкурсу "Євробачення". На ньому учасники 18 країн виступлять зі своїми піснями. Організатори конкурсу визначили порядок виступу всіх учасників та затвердили їхні пісні.

За даними Чернігівського обласного центру громадського здоров’я, cтаном на 18 травня в області щеплено першою та другою дозою 22639 людей, з них: - вакциною AstraZeneca щеплено першою дозою 17846; - вакциною CoronaVac – 1931 (1706 перша доза + 225 друга доза)
Магній відомий, як один із найголовніших мікроелементів на планеті. Організм жінки має потребу в багатьох мікроелементах та вітамінах, тому важливо вживати їх достатню кількість.

У рамках «VI Глобального тижня безпеки дорожнього руху ООН» у центрі Чернігова організували просвітницький флешмоб. 12-річна Вероніка навчається у третій міській школі. Каже, кататися на велосипеді весело, але іноді небезпечно.


 (18 травня 2021 11:54) На Корюківщині створили ще один дитячий будинок сімейного типуВідтепер на Корюківщині два будинки сімейного типу. Один у самій Корюківці, другий у сільській місцевості. Новий будинок сімейного типу створила 48-річна мама, у якої до цього часу була прийомна родина з чотирма дітьми.
(18 травня 2021 11:54) На Корюківщині створили ще один дитячий будинок сімейного типуВідтепер на Корюківщині два будинки сімейного типу. Один у самій Корюківці, другий у сільській місцевості. Новий будинок сімейного типу створила 48-річна мама, у якої до цього часу була прийомна родина з чотирма дітьми. Коментарів: 1
Коментарів: 1
 (18 травня 2021 11:32) В Чернігові виявлено реабілітаційний центр, де перебували в неволі два десятки людейСьогодні в мікрорайоні Нова Подусівка у приватному будинку із заґратованими вікнами правоохоронці припинили діяльність так званого «реабілітаційного центру з ідеологічним одужанням», де проти волі утримувалися два десятки людей віком від 18 до 50-ти років.
(18 травня 2021 11:32) В Чернігові виявлено реабілітаційний центр, де перебували в неволі два десятки людейСьогодні в мікрорайоні Нова Подусівка у приватному будинку із заґратованими вікнами правоохоронці припинили діяльність так званого «реабілітаційного центру з ідеологічним одужанням», де проти волі утримувалися два десятки людей віком від 18 до 50-ти років. (18 травня 2021 11:19) Зустріч через 40 років: легендарна художниця на фестивалі в ЧерніговіПриїзд до Чернігова 91-річної художниці, шістдесятниці Галини Севрук став головною подією на фестивалі монументального мистецтва. Легендарну мисткиню запросили на презентацію її панно «Давній Чернігів» або «Міста-побратими».
(18 травня 2021 11:19) Зустріч через 40 років: легендарна художниця на фестивалі в ЧерніговіПриїзд до Чернігова 91-річної художниці, шістдесятниці Галини Севрук став головною подією на фестивалі монументального мистецтва. Легендарну мисткиню запросили на презентацію її панно «Давній Чернігів» або «Міста-побратими». (18 травня 2021 10:56) Ботулізм: які симптоми та як уберегтисяДві людини померли від ботулізму минулого тижня в Чернігові. Які симптоми хвороби та як уберегтися? Про це говорили з Оксаною Баластрик, лікаркою-інфекціоністом.
(18 травня 2021 10:56) Ботулізм: які симптоми та як уберегтисяДві людини померли від ботулізму минулого тижня в Чернігові. Які симптоми хвороби та як уберегтися? Про це говорили з Оксаною Баластрик, лікаркою-інфекціоністом. (18 травня 2021 10:37) Стало відомо, коли у Чернігові в школярів завершиться навчальний рікУ Чернігові навчальний рік закінчиться 4 червня. Учні 9-тих класів отримають атестати 9 червня. А випускники 11 класів - 30 червня та 1 липня. Про це повідомила заступниця начальника управління освіти Олена Горна на розширеній нараді у міськраді.
(18 травня 2021 10:37) Стало відомо, коли у Чернігові в школярів завершиться навчальний рікУ Чернігові навчальний рік закінчиться 4 червня. Учні 9-тих класів отримають атестати 9 червня. А випускники 11 класів - 30 червня та 1 липня. Про це повідомила заступниця начальника управління освіти Олена Горна на розширеній нараді у міськраді. (18 травня 2021 10:17) У Чернігові повільно зменшуються показники covid-19Станом на 18 травня Чернігівська область, як і більшість областей України, знаходиться у жовтій зоні за рівнем епідемічної небезпеки по розповсюдженню коронавірусної інфекції. По місту Чернігову за дев’ятнадцятий тиждень стабільно, але повільно зменшується кількість захворілих та госпіталізованих.
(18 травня 2021 10:17) У Чернігові повільно зменшуються показники covid-19Станом на 18 травня Чернігівська область, як і більшість областей України, знаходиться у жовтій зоні за рівнем епідемічної небезпеки по розповсюдженню коронавірусної інфекції. По місту Чернігову за дев’ятнадцятий тиждень стабільно, але повільно зменшується кількість захворілих та госпіталізованих. (18 травня 2021 10:17) Хто виступить у першому півфіналі Євробачення: список виконавців і пісень18 травня о 22:00 розпочнеться перший півфінал щорічного пісенного конкурсу "Євробачення". На ньому учасники 18 країн виступлять зі своїми піснями. Організатори конкурсу визначили порядок виступу всіх учасників та затвердили їхні пісні.
(18 травня 2021 10:17) Хто виступить у першому півфіналі Євробачення: список виконавців і пісень18 травня о 22:00 розпочнеться перший півфінал щорічного пісенного конкурсу "Євробачення". На ньому учасники 18 країн виступлять зі своїми піснями. Організатори конкурсу визначили порядок виступу всіх учасників та затвердили їхні пісні. (18 травня 2021 10:03) Імунізація в області: за добу першою дозою щеплено 110 осіб, другою – 305За даними Чернігівського обласного центру громадського здоров’я, cтаном на 18 травня в області щеплено першою та другою дозою 22639 людей, з них: - вакциною AstraZeneca щеплено першою дозою 17846; - вакциною CoronaVac – 1931 (1706 перша доза + 225 друга доза)
(18 травня 2021 10:03) Імунізація в області: за добу першою дозою щеплено 110 осіб, другою – 305За даними Чернігівського обласного центру громадського здоров’я, cтаном на 18 травня в області щеплено першою та другою дозою 22639 людей, з них: - вакциною AstraZeneca щеплено першою дозою 17846; - вакциною CoronaVac – 1931 (1706 перша доза + 225 друга доза) (18 травня 2021 09:56) Тиждень безпеки дорожнього руху розпочатоУ рамках «VI Глобального тижня безпеки дорожнього руху ООН» у центрі Чернігова організували просвітницький флешмоб. 12-річна Вероніка навчається у третій міській школі. Каже, кататися на велосипеді весело, але іноді небезпечно.
(18 травня 2021 09:56) Тиждень безпеки дорожнього руху розпочатоУ рамках «VI Глобального тижня безпеки дорожнього руху ООН» у центрі Чернігова організували просвітницький флешмоб. 12-річна Вероніка навчається у третій міській школі. Каже, кататися на велосипеді весело, але іноді небезпечно.






